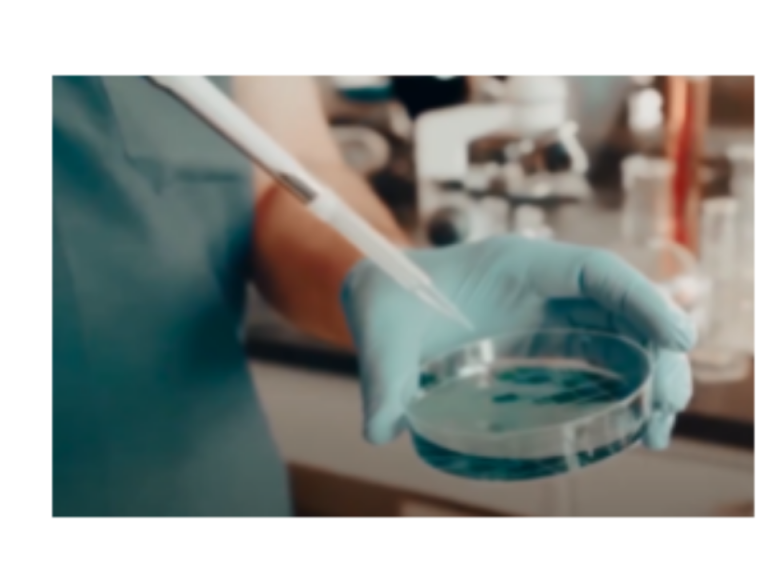

Por Prof. Dr. Marcos Roberto Ruiz
A ciência, de forma geral, está sofrendo uma grande revolução, mesmo antes da pandemia muitas tecnologias já estavam à disposição da nova indústria química. Os produtos químicos de todas as áreas estão sendo modificados para atender o desenvolvimento humano, em especial os saneantes, que são essenciais no combate aos microrganismos. Estes produtos já não podem mais ter a formulação do século passado, ou seja, precisam ser modificados com as novas tecnologias, para garantir um melhor desempenho frente aos novos microrganismos.
Diante da crise global causada pela pandemia, onde o mundo precisa retomar o desenvolvimento econômico, as pessoas necessitam voltar as suas atividades de trabalho com segurança, é preciso que novas tecnologias atendam esse momento. Novos produtos que são resultados de pesquisas que comprovam aumento de eficácia em relação ao combate a vírus e bactéria precisam sair das instituições de ensino o mais rápido para a prateleira dos consumidores.
Umas das tecnologias químicas que estão em alta, é a nanotecnologia, que pode ser compreendida como a tecnologia que constroem estruturas e novos materiais a partir dos elementos ou átomos. A finalidade principal é que esses novos materiais devem possuir maior estabilidade e propriedades superiores a suas formas originais, a explicação é que os elementos possuem comportamento diferenciado na escala nanométrica.
Em especial temos a síntese de nanopartículas, com alto potencial de aplicação em produtos como, roupas, combustíveis, produtos de limpeza, alimentos, entre outros. Nos centros de pesquisa e desenvolvimento, alguns produtos com essas características já foram testados e apresentaram resultados que credenciam para inserção imediata no mercado.
Um exemplo é o desenvolvimento de saneantes com ação potencializada pelas nanopartículas de prata, estas possuem propriedades bactericidas e antivirais para limpeza e higienização de ambientes de alto risco de contaminação, como hospitais e clínicas médicas.
Exemplos de aplicações das nanopartículas de prata e cobre foram desenvolvidas por aluno (a)s do curso Técnico em Química, que comprovaram a ação bactericida e antiviral em desinfetante (processo de patente no INPI) e sabão lava-roupas concentrado, as nanopartículas de prata estão se destacando como uma importante classe de nanomateriais. Já é de conhecimento que propriedades como cor, a quantidade, o tamanho, a estabilidade, as ações antimicrobianas das nanopartículas de prata dependem e diferem conforme o formato físico da nanopartícula sintetizada.
Em ambos trabalhos, as nanopartículas foram sintetizadas separadamente, por rota sintética laboratorial e caracterizada por técnicas instrumentais, como espectrofotometria UV-Vis e analisador de partículas. A fabricação dos saneantes seguiu formulações de base atuais e foram inseridas as nanopartículas para efeito potencializador.
Para comprovação da eficácia dos novos saneantes foram realizadas análises microbiológicas com as principais bactérias do meio hospitalar, onde a eliminação ocorreu de forma completa em todos os ensaios.
Este exemplo demonstra a importância das novas tecnologias para o desenvolvimento de produtos, que serão capazes de atender as necessidades impostas por novos cenários e mudanças que o mundo está atravessando.
Algumas imagens que foram utilizadas no pitch dos produtos:





Autor: Prof. Dr. Marcos Roberto Ruiz (Químico, Mestre em Química Analítica e Doutor em Ciência e Tecnologia dos Materiais, docente do Curso Técnico em Química do SENAI-SP, com atuação no desenvolvimento de Projetos Inovadores.)